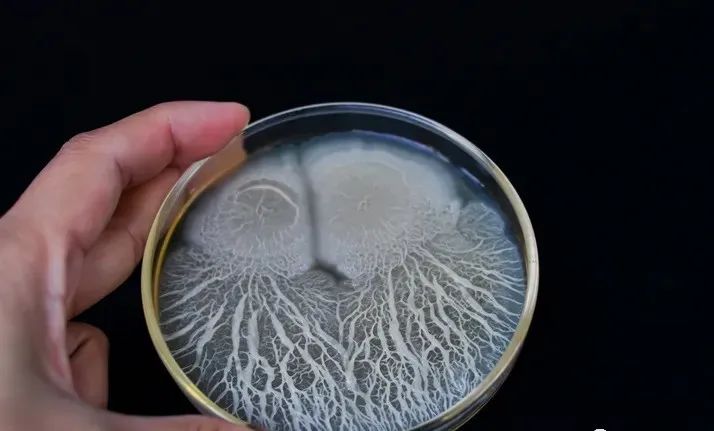

…ΫΕΪΩΐΖα…ζΈοΩΤΦΦ”–œόΙΪΥΨ
ΒΊ÷ΖΘΚ…ΫΕΪ Γ.Χ©Α≤ –.Χ©«Α
ΒγΓΓΓΓΜΑΘΚ0538-8505866
¥ΪΓΓΓΓ’φΘΚ0538-8505966
≤ΤΗΜ»»œΏΘΚ18660886576

ΡπΨΤΫΆΡΗΜρ’ΏΟφΑϋΫΆΡΗΘΚ”…”ΎΤδΉςΈΣΟβ“Ώ¥ΧΦΛΦΝΚΆΙΊΦϋ”Σ―χ‘ω«ΩΦΝΒΡ«Ω¥σ–‘ΡήΘ§ΫΆΡΗ“―≥…ΈΣΥ°≤ζ―χ÷≥Υ«Νœ÷–ΒΡ–¬≥…
Ζ÷ΓΘ
ΉνΫϋΘ§ΫΆΡΗ“―≥…ΈΣΥ°≤ζ―χ÷≥Υ«Νœ÷–ΒΡ“Μ÷÷–¬≥…Ζ÷Θ§’β“ΣΙιΙΠ”ΎΥϋΉςΈΣ–μΕύ”ψœΚΒΡΟβ“Ώ¥ΧΦΛΦΝΚΆΙΊΦϋ”Σ―χ‘ω«ΩΦΝΒΡ«Ω
¥σ–‘ΡήΓΘά¥Ή‘ΑΔ≤ΖΕ≈ά’ΑΔΤκΉ»ΙζΆθ¥σ―ßΚΆά≠Ϋή…≥Κ’¥σ―ßΘ®”ΓΕ»ΡαΈς―«Θ©ΒΡ―–ΨΩ»Υ‘±ΖΔ±μΝΥ“ΜΤΣΩΤ―ßΤά¬έΘ§ΥϊΟ«Χ÷¬έ
ΝΥΫΆΡΗ‘ΎΥ°≤ζ―χ÷≥÷–ΒΡ”Σ―χΚΆΟβ“Ώ¥ΧΦΛ Ι”ΟΒΡ≤ΜΆ§ΖΫΟφΓΘ
ΫΆΡΗ±ΜΕ®“εΈΣ“Μ÷÷ΒΞœΗΑϊ’φΚΥ…ζΈοΘ§Κ§”–ΡΛΫαΚœΒΡœΗΑϊΤςΘ§»γΘΚœΏΝΘΧεΓΔœΗΑϊΚΥΚΆΡΎΡΛœΒΆ≥ΓΘ≤ΜΆ§÷÷άύΒΡΫΆΡΗΘ§
»γΘΚΡπΨΤΫΆΡΗ , »ιΥαΩΥ¬≥Έ§ΫΆΡΗ , φΏ‘≤ΫΆΡΗ , ΫΆΡΗΨζΚΆ«ρΡβΫΆΡΗ±Μ”ΟΉςΕ‘œΚΚΆ”ψάύΥ«Νœ÷–ΒΡΒΑΑΉ÷ ά¥‘¥ΓΘ

‘Ύ―χ÷≥“Β÷– Ι”ΟΫΆΡΗΉςΈΣΥ«ΝœΘ§≤Δ≤Μ «“ΜΗω–¬œκΖ®Θ§Ή‘1980Ρξ¥ζ“‘ά¥Θ§“―Ψ≠Ϋχ––ΝΥ“ΜœΒΝ– Β―ι“‘―ι÷ΛΤδΙΠ–ßΓΘΫΆΡΗ
«“Μ÷÷ΗΜΚ§ΒΑΑΉ÷ ΒΡΒΞœΗΑϊ…ζΈοΘ§ΨΏ”–ΒΆΕΨ–‘«±ΝΠΘ§Ω…“‘‘ΎΕύ÷÷Μυ÷ …œ…ζ≥ΛΓΘ
¥ΥΆβΘ§―–ΨΩ»Υ‘±±®Ηφ≥ΤΘΚΒ±‘Ύ¬όΖ«”ψΥ«Νœ÷–≤Ι≥δ”ψΖέ ±Θ§ΡπΨΤΫΆΡΗΩ…“‘ΉςΈΣ“Μ÷÷”––ßΒΡΧλ»ΜΒΑΑΉ÷ ά¥‘¥ΓΘ“ρΈΣΥϋΟ«
ΧαΗΏΝΥ…ζ≥Λ–ß¬ ΓΔ”ψάύΒΡΩΙ≤Γ–‘ΓΔΥ°÷ ΚΆΈΔ…ζΈο»Κ¬δΒΡΕύ―υ–‘ΓΘ
Ψί―–ΨΩ»Υ‘±≥ΤΘ§ Ρν÷ιΨζ τΒΡΫΆΡΗΩ…“‘”––ßΧφ¥ζΫϋ40%ΒΡ”ψΖέΘ§Εχ≤ΜΜα”Αœλ…ζ≤ζΜρ…ζ≥Λ–ß¬ ΓΘΆ§―υΘ§―–ΨΩΜΙ±μΟςΘ§‘Ύ
Κγς°”ψΥ«Νœ÷– Ι”Ο100%ΒΡΫΆΡΗΒΑΑΉΘ§ΜαΒΦ÷¬…ω‘ύ÷–≥ωœ÷ΈΘœ’ΝΩΒΡΡρΥαΚΆΤΕ―ΣΓΘ
Νμ“ΜΖΫΟφΘ§ΡπΨΤΫΆΡΗΚ§”–ΦΗ÷÷Οβ“Ώ¥ΧΦΛΜ·ΚœΈοΘ§±μΟςΥυ”–ΫΆΡΗΕΦΩ…Ρή”ΟΉςΚΘωτ ( Sparus aurata ) Β»”ψάύΥ«Νœ÷–ΒΡ
Χλ»ΜΟβ“Ώ¥ΧΦΛΦΝΓΘ
Υ°≤ζ―χ÷≥÷–ΉνΙψΖΚ Ι”ΟΒΡ“φ…ζΨζΘ§Αϋά® Ι”Ο¥χ”–―ΩφΏΗΥΨζ τœΗΨζΒΡΫΆΡΗΓΘ―–ΨΩ±μΟςΘ§’φΨζΕύΧ« «“φ…ζ‘ΣΒΡ≥…Ζ÷Θ§±Μ
»œΈΣ «ΩΊ÷ΤΥ°≤ζ―χ÷≥ΫΓΩΒΚΆ…ζ≥ΛΧθΦΰΒΡ”Σ―χ≥…Ζ÷ΓΘ
ΤδΥϊ―–ΨΩ±®Ηφ≥ΤΘ§”ΓΕ»ΟςΕ‘œΚ(Fenneropenaeus indicus)‘ΎΈΙ ≥ά¥Ή‘ΚΘ―σΫΆΡΗΒΡΠ¬-ΤœΨέΧ« ±Θ§ΤδΟβ“ΏΖ¥”ΠΚΆ…ζ≥Λœ‘
Ή≈ΗΡ…ΤΓΘ
“Μ–©ΫΆΡΗΨζΈο÷÷Θ§»γΘΚΚΚΥΙΒ¬ΑΆ œΫΆΡΗΨζ(Debaryomyces Hansenii)Θ§ΚλΫΆΡΗ(Rhodotorula sp)Θ§ΟΖΤφΫΆΡΗΨζΚΆΤΛΉ¥
ΥΩφΏΫΆΡΗ(Trichosporon cutaneum) Θ§Ά®≥Θ‘Ύ”ψœΚάύΒΡ≥ΠΒά÷–ΖΔœ÷Θ§“―÷ΣΩ…“‘Φ”ΥΌ”ψœΚάύœϊΜ·œΒΆ≥ΒΡΖΔ’ΙΓΘ

ΫΆΡΗΚΆΈΔ‘ε «Ω…”Ο”ΎΜνΒΡΥ«Νœ≈ύ―χΘ® ¬±≥φ ΓΔ¬÷≥φΓΔηψΉψάύΘ©ΒΡ ≥Έοά¥‘¥ΓΘΗυΨί―–ΨΩ»Υ‘±ΒΡΥΒΖ®Θ§Β±ΧαΙ©ΤΓΨΤΫΆΡΗ
ΉςΈΣ÷ς“ΣΥ«Νœ ±Θ§“―Ψ≠±®ΒάΝΥΕ‘¬±≥φ≤ζ…ζ÷Ί¥σ”ΑœλΓΘ
Νμ“ΜΖΫΟφΘ§“ΜœνΕ‘¬÷≥φΉνΦ―…ψ ≥¬ ΚΆ…ψ ≥ΤΒ¬ ΒΡ―–ΨΩœ‘ ΨΘ§¬÷≥φΒΡ Β±…ψ ≥¬ «ΤΫΨυ0.3ΩΥΟφΑϋΫΆΡΗΕ‘100Άρ÷Μ¬÷
≥φΓΘΉνΚσΘ§―–ΨΩ»Υ‘±±®ΗφΒΡ―–ΨΩ±μΟςΘ§ΫΆΡΗ‘ωΦ”ΝΥηψΉψάύΕ·Έο‘Ύ≈ύ―χΈο÷–ΒΡΟήΕ»Θ§≤Δ«“Ω…Ρή≥…ΈΣΈ¥ά¥≤Ι≥δ’β–©…ζΈο
ΧεΈΙ―χΒΡ«±‘ΎΚρ―Γ’ΏΓΘ
―–ΨΩ»Υ‘±«ΩΒςΘΚΓΑ’ΐ»γΚήΕύΉ®“Β»Υ ΩΥυΧ÷¬έΒΡ“Μ―υΘ§ΫΆΡΗ‘ΎΥ°≤ζ―χ÷≥÷–ΒΡ”Π”Ο“―Ψ≠±δΒΟΖ«≥Θ÷Ί“ΣΚΆΩ…––Θ§Ω…“‘ΉςΈΣ
ΒΑΑΉ÷ ΒΡΧφ¥ζά¥‘¥Θ§Ρ…»κΥ«Νœ––“ΒΓΘΓ±
Ά§―υΘ§ΫΆΡΗΩ…”ΟΉςΜν ≥Θ®¬±≥φΓΔ¬÷≥φΓΔηψΉψάύΘ©≈ύ―χΒΡ”–«ΑΆΨΒΡ ≥ΈοΘΜ≤ΔΉςΈΣ“φ…ζΨζΧαΙ©ΗϋΚΟΒΡ≤Γ‘≠ΧεΟβ“ΏΝΠΘ§“‘
ΦΑΗΡ…ΤΥ°≤ζ―χ÷≥ΉςΈοΒΡΥ°÷ ΓΘ»ΜΕχΘ§ΨΓΙή”–«±‘ΎΒΡΚΟ¥ΠΘ§―–ΨΩ»Υ‘±Ϋ®“ι≤Μ“Σ‘ΎΥ°≤ζΥ«Νœ÷–Άξ»Ϊ”ΟΫΆΡΗ¥ζΧφΤδΥϊ÷÷άύ
ΒΡΒΑΑΉ÷ ΓΘ“ρΈΣΆξ»ΪΧφ¥ζΘ§Ω…ΡήΜαΕ‘Ρ≥–©”ψάύΒΡ…ωΙΠΡή≤ζ…ζΗΚΟφ”ΑœλΓΘ